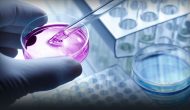
抑制miR21、體內(nèi)偶聯(lián)白蛋白的RNAi 抑制miR21、體內(nèi)偶聯(lián)白蛋白的RNAi

昨天美國生物技術(shù)公司Fate公布了其誘導性多能干細胞(iPSC)改造NK細胞療法FT516和CAR-NK療法FT596的一期臨床劑量爬坡結(jié)果。11位淋巴瘤患者使用不同劑量FT516有8位應答、其中6位為CR。14位使用FT596單方或與美羅華聯(lián)用患者有10位應答,其中7位為CR。所有應答都發(fā)生在中高劑量組,最低劑量無效。這兩個療法耐受性良好,沒有達到毒性限制劑量、沒有發(fā)生異體細胞療法常見的GvHD。
Continue reading …
今天美國生物技術(shù)公司Relay在公布第二季度報告時宣布將與me-too大師EQrx達成戰(zhàn)略合作,在全球范圍內(nèi)開發(fā)確證靶點的抗腫瘤新藥。Relay將負責臨床批件前的發(fā)現(xiàn)和臨床前開發(fā)工作,EQrx將負責臨床開發(fā)、新藥報批、和商業(yè)化。二者共同擔負研發(fā)費用、利潤也平分。他們將從單個項目合作開始,但可能在自愿基礎(chǔ)上擴大到更多靶點的開發(fā)。
Continue reading …
今天輝瑞宣布將以6.5億首付、3.5億股票認購,加上14億潛在里程金收購蛋白降解先驅(qū)Arvinas開發(fā)的雌激素受體PROTAC藥物ARV-471部分權(quán)益。二者將共同負責這個藥物的臨床開發(fā)、利潤也5/5分成,
Continue reading …
今天韓國科學家在《ACS Nano》發(fā)表一篇展現(xiàn)現(xiàn)代新藥發(fā)現(xiàn)技術(shù)的文章。這個工作設(shè)計一個靶向miRNA miR-21的RNAi
Continue reading …
今天施貴寶宣布將以6.5億首付(包括對衛(wèi)材的2億研發(fā)投入)、24.5億潛在里程金與衛(wèi)材達成合作開發(fā)其ADC藥物MORAb-202的協(xié)議。
Continue reading …
今天著名化學生物學大佬Schreiber創(chuàng)建的Kojin Therapeutics獲得Polaris Partners領(lǐng)投的6000萬美元A輪支持
Continue reading …
今天是2021年ASCO正式開幕第一天,主要進展的摘要我們前幾天已經(jīng)討論過、幾個late breakers也都是大家熟知的成熟產(chǎn)品,不再贅述
Continue reading …
最近法國科學家在《自然綜述臨床腫瘤》雜志發(fā)表一篇綜述文章介紹現(xiàn)在溶瘤病毒以外溶瘤療法的進展和前進方向。現(xiàn)在非病毒溶瘤療法包括物理手段如熱溶瘤(激光、微波、輻射等)、冷溶瘤、電溶瘤、光溶瘤,和化學手段如溶瘤多肽(如LTX-301)等。上述這些局部物理和化學療法可以和局部/系統(tǒng)給藥的免疫療法(如PD-1藥物)聯(lián)用,也有遞送技術(shù)試圖解決溶瘤藥物系統(tǒng)給藥問題。
Continue reading …
ASCO21年會摘要今天美東時間5點上線,有些記者因為事先看到摘要所以已經(jīng)做了一些總結(jié)。免疫療法最大的新進展包括施貴寶Lag3抗體relatlimab與O藥組合在一線惡黑延長PFS、默沙東類似產(chǎn)品favezelimab也報道了一些早期療效
Continue reading …
今天施貴寶宣布將以2億首付、13.6億潛在里程金收購Agenus還在臨床前的TIGIT雙抗AGEN1777。施貴寶將負責這個產(chǎn)品的全部開發(fā)和商業(yè)化,但Agenus有參與開發(fā)與自己其它產(chǎn)品組合的臨床研究和美國的共同推廣選擇。Agenus計劃今年第二季度遞交IND,施貴寶將把這個產(chǎn)品作為高優(yōu)先IO藥物開發(fā)。
Continue reading …
今天輝瑞宣布其BCMA/CD3雙抗elranatamab 的MagnetisMM-3 臨床試驗因為發(fā)生3例外周神經(jīng)損傷而暫停招募患者。這個試驗招募約150位使用至少三種主要療法、包括部分使用過BCMA藥物進展后的多發(fā)性骨髓瘤患者。這個試驗今年二月開始,目前約100位使用了elranatamab、從該療法受益的患者可以繼續(xù)用藥。一期臨床中這個藥物的應答率高達83%,本來這個二期試驗是準備作為加速審批上市的主要根據(jù)。
Continue reading …

























 微信號:美中藥源
微信號:美中藥源